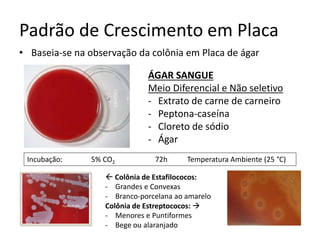
Padrão de Crescimento em Placa
• Baseia-se na observação da colônia em Placa de ágar
ÁGAR SANGUE
Meio Diferencial e Não seletivo
- Extrato de carne de carneiro
- Peptona-caseína
- Cloreto de sódio
- Ágar
Incubação: 5% CO2 72h Temperatura Ambiente (25 °C)
 Colônia de Estafilococos:
- Grandes e Convexas
- Branco-porcelana ao amarelo
Colônia de Estreptococos: 
- Menores e Puntiformes
- Bege ou alaranjado

O documento descreve as características morfológicas, bioquímicas e de crescimento de bactérias Gram-positivas de importância clínica, incluindo estafilococos, estreptococos e enterococos. Detalha os principais gêneros e espécies destas bactérias, as doenças causadas e os testes utilizados para sua identificação.